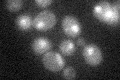
YBR175W
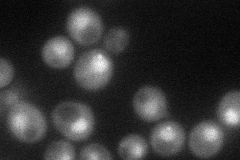
YBR175W
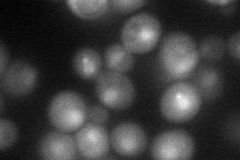
YBR175W
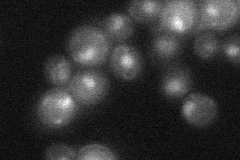
YBR175W
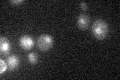
YBR175W

View description
Essential subunit of the COMPASS (Set1C) complex, which methylates histone H3 on lysine 4 and is required in transcriptional silencing near telomeres; WD40 beta propeller superfamily member and ortholog of mammalian WDR5
Localization:
Intensity:
Fold change:
Significance:
-
C’ GFP library in SD
nucleus17.14 -
N' NOP1pr-GFP in SD
punctate,nucleus45.4491 -
N' TEF2pr-mCherry in SD
punctate,nucleus47.1259 -
N' NATIVEpr-GFP in SD
punctate,nucleus27.464 -
N' TEF2pr-VC and Cyto-VN in SD

#N/A0 -
C’ GFP library in SD+DTT

nucleus19.671.14No -
C’ GFP library in SD+H2O2

nucleus23.861.39No -
C’ GFP library in Starvation Media
nucleus23.111.34No -
C’ GFP library on the background of Pup2-DaMP

nucleus -
C’ GFP library on the background of CCT mutant

nucleus17.58371.02542No
